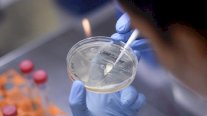
لقاح كورونا... احذروا الآمال الخادعة!

إيلاف من لندن: قال تقرير صحفي نشر في لندن، إنه الأطباء العامين سيبدأون تقديم لقاح كورونا في عيد الميلاد في خطة سريعة التنفيذ تهدف بالدرجة الأولى لحماية النظام الصحي NHS.
ويبدأ الأطباء ضمن الخطط التي سيعلنها وزير الصحة مات هانكوك تلقيح الممرضات الأجانب والبريطانيين الأكثر ضعفا في خلال كل أيام الأسبوع بدون عطلة خلال منتصف الشتاء.
أفادت صحيفة (ذا صن) أن وزير الصحة مات هانكوك سيطرح خططاً الأسبوع المقبل لعشرات من مراكز اللقاحات حتى يتمكن أكثر من 100 ألف شخص من تلقيحة كل يوم.
وسيتم تسريع 3000 وحدة متنقلة أخرى في جميع أنحاء البلاد لتقديم العلاج إلى دور الرعاية وتلك الموجودة في الفئات عالية الخطورة.
بدء التلقيح
وجاء الإعلان عن بدء التلقيح، في الوقت الذي دخلت فيه شركتا فايزر وجامعة أكسفورد في مراحل الاختبار النهائية مع بيانات تشير إلى أنه يمكن بدأ التلقيح في غضون أسابيع.
وتستعد الحكومة البريطانية لإنشاء مركز تحصين مخصص للتلقيح في كل مدينة رئيسية. وقالت كيت بينغهام ، رئيسة فريق عمل اللقاحات التابع للحكومة، في وقت سابق من هذا الأسبوع إن التطعيمات لديها "إمكانية أن تكون جاهزة قبل نهاية العام".
لكنها حذرت من أنه سيتم تصنيع أربعة ملايين جرعة فقط من لقاح أكسفورد بحلول عيد الميلاد، مع احتمال توفر عشرة ملايين جرعة من لقاح فايزر بحلول يناير.
اقتراح الحكومة
وهذا التقدير، الذي لا يرقى إلى مستوى اقتراح الحكومة في مايو بإمكانية توفير 30 مليون جرعة بحلول سبتمبر، يعني أن التلقيح الجماعي بين عمال هيئة الصحة الوطنية العامة NHS وكبار السن لن يكون قابلاً للتحقيق بعد.
وخططت السيدة بينغهام، قيصر اللقاحات في المملكة المتحدة، لشراء ستة لقاحات مختلفة، تصل إلى أكثر من 350 مليون جرعة، لكن ليس هناك ما يضمن نجاح أي منها.
وسيتعين أيضًا تقديمها جميعًا للموافقة عليها من قبل وكالة تنظيم الأدوية ومنتجات الرعاية الصحية (MHRA) ولكن لم يُعرف بعد كم من الوقت سيستغرق ذلك.
فرصة صغيرة
وقال البروفيسور أندرو بولارد ، من جامعة أكسفورد إن هناك "فرصة صغيرة" لأن لقاحها سيكون جاهزًا قبل عيد الميلاد. وأضاف: "الخطوة الأولى هي الوصول إلى النقطة التي يمكننا فيها إجراء تحليل ومعرفة ما إذا كان اللقاح يعمل أم لا. أنا متفائل بأننا قد نصل إلى هذه النقطة قبل نهاية هذا العام".
ومن جهته، قال رئيس هيئة الخدمات الصحية الوطنية في إنكلترا، السير سيمون ستيفنز، إن الخدمة الصحية جاهزة وعلى أهبة الاستعداد لتقديم برنامج تطعيم شامل لـ Covid بحلول عيد الميلاد.
وكانت الحكومة البريطانية خلال الصيف عن إبرام صفقة مع استرا زينيكا AstraZeneca، وهي شركة الأدوية التي تمتلك حقوق لقاح أكسفورد - لطرح 30 مليون جرعة بحلول سبتمبر إذا ثبت أنها فعالة.

التعليقات